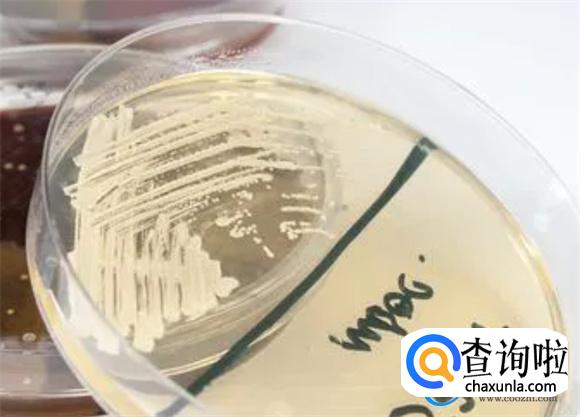

最佳回答
本文由作者推荐
简要回答
霉菌、真菌念珠菌都属于真菌,但它们又是不同的类型和类别。霉菌属于一种多细胞的真菌,主要是以菌丝的状态形存在。目前能够在多个环境当中生存和繁殖,真菌属于真菌,通常是以单细胞的形态存在,像常见的酵母菌。
详细内容
- 01
念珠菌是什么
念珠菌属于真菌当中的一种,主要是以酵母菌的形态存在的病原菌。它可能会导致人们出现感染,有时候动物一旦接触到念珠菌之后也会出现感染。人们在现实生活中,一旦感染了念珠菌之后,需要及时的治疗,避免引发并发症。
- 02
霉菌、念珠菌、真菌的形态不同
霉菌是多细胞的,真菌通常是以菌丝的状态存在。念珠菌属于单细胞的真菌,是以酵母菌的形态存在。真菌其实是可以为多细胞真菌也可以为单细胞的真菌。
- 03
霉菌念珠菌真菌的病原性不同
霉菌和念珠菌通常是人体内的病原菌,可以引起一系列的疾病和感染的情况。在现实生活中,霉菌感染和链球菌感染都需要及时的治疗,当然真菌它也可以形成为病原菌。一旦形成为病原菌的时候会引发感染,需要及时治疗。
广告位
点击排行
- 2 排行
- 3 排行
- 4 排行
- 5 排行
- 6 排行
- 7 排行
- 8 排行
- 9 排行
- 10 排行
热点追踪
广告位

